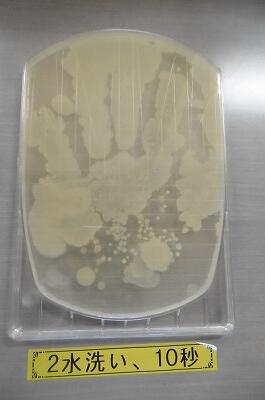

お知らせ/学びの丘日記
小さな旅㉑【終業の日編~2~】
今年もやります!
中学部2年生「お笑いクリスマス会!はじまるよ~!」
【パチパチパチパチ・・・】
【トップバッター、女子2人組・・・】
【歌って、踊って・・・】
【みんな大喜び!】
続いては、お待たせしました!
【謎のMr..I君、圧巻のダンスパフォーマンス!!そこに・・・】
【ライバル登場!?】
【仲良くなって・・】
【一緒にDANCING!この後も・・】
【濃いキャラクターが・・】
【続々登場し・・・】
【みんなで大笑いしたり、し~んと静まりかえったり・・。とってもいいクラスですね!】
短い時間でしたが、年忘れの楽しい一時となったようです。
~「終業の日特集」まだまだ続きます!~
小さな旅㉑【終業の日編】
【冷たい水を使い、汚れた粘土板を洗う2年生。】
「小さな旅」。PART21。
終業の日特集をお届けしていきます。(昨日の様子も含まれます。)
まずは、「終業の日ある!ある!」コーナーから・・・
【小学部6年生も・・・】
【中学部3年生も・・・、たまりにたまった荷物やプリントを整理中!】
【君、君!重量オーバーです!つかまりますよ!!】
【小学部1年生は、冬休みに読む本を選定中!】
【本が大好きな1年生。冬休みもたくさん読むことでしょう!】
【中学部1年生は・・・】
【冬休みの計画を作成中!】
13日間もの長い休み。計画的に過ごしていきましょう!
~つづく~
次回・・・
【中学部お楽しみ会!!(クリスマス会)お楽しみに~!】
2学期終業式(12/23)

終業式の様子をお届けします。
【児童・生徒代表作文発表「2学期を振り返って」】
【校長先生の話】
【努力は必ず報われる!もし報われない努力があるのならば、それはまだ努力と呼べない。~王 貞治~】
【「未来の自分を考え、描いてみる」校長先生から子ども達へ、冬休みの宿題です。】
【校歌斉唱】
2学期を締めくくる大切な式。寒い体育館、長時間となりましたが、子ども達は、最後まで立派な態度で臨むことができました。
式の後は・・・
【2学期がんばった児童生徒の表彰です。】
~終業式の様子「おしまい!」~
この後・・・
「終業の日」特集!お届けします。お楽しみに~!
給食&上学ニュース!(12/23)
最後、最後とくどいようですが、2学期最後の給食です!
【今日のメニュー】
〇チキンライス、牛乳
〇オムレツ
〇白菜スープ、クリスマスデザート
明後日はクリスマスですね!
今日の献立も・・・

【クリスマスメニューです!】
それではみなさん、ご一緒に・・・

【メリークリスマス!】
給食に携わっていただいている全ての皆様、2学期も、栄養、そして愛情たっぷりの給食を提供していただき、ありがとうございました!3学期もどうぞよろしくお願いします。
見守りありがとうございました!(12/23)
本日で長い2学期が終了します。
【小雪舞う、寒い、寒い、最終日の朝です・・】
暑い日も、寒い日も、雨の日も毎朝、子ども達の安心・安全を見守っていただいた皆様・・・、
【誠にありがとうございました!】
来年もどうぞよろしくお願い致します。
小さな旅⑳(学期末編)
2学期最後の小さな旅、「学期末あるある特集」です!
学期末といえば・・・
【2学期間、とってもよく頑張ったごほうびのお楽しみ会!(クリスマス会)】
各学年、どんなイベントが行われたのでしょう!?
【3年生:大盛り上がりのフルーツバスケット!】
【5年生教室にて・・・】
【まずは、球技の王道!みんな大好き?!ドッジボール・・・。そして、次は・・・】
【せ・ん・ぐ・ま・き・・・】
【投げると拾うのが大変なので、くじ引きにしたみたいですね!みんながねらう商品は・・・?】
【もちろん!】
【宅習パス券・・・。ゲットして大喜びのラッキーガール!】
小学部1年生は・・・
【運動場で、缶(ボール)蹴り中 ・・・】
【鬼に見つからないように、そろり、そろり・・・】
【ドキドキ感、ワクワク感が伝わってきますね!】
最後に6年生・・・
【これも懐かしい遊び「けいどろ」!(地域によってはどろけい)思いっきり運動場を駆け回っていました!】
~つづく~
うきうき、わくわく、クッキング~!
先日、中学部1年生の「玉子焼きづくり」をお伝えしましたが、今回は・・・、
【小学部6年生です!何を作るのでしょうか?】
【ジャガイモを使った料理ですね!】
では、6年生がとっても楽しみにしていた、うきうき、わくわくクッキング~!ご覧ください。
【班で協力して作っていきます。何を作っているのか想像しながらご覧ください。】
【手慣れた感じでフライパンを持つ少女・・・。】
【もうお分かりですね!】
【完成で~~す!すぐに食べたいところでしょうが・・・】

【さすが6年生!お世話になっている先生方におすそ分け・・・】
それでは、みんなで・・・
【いただきま~す!】
【では、私もアスパラ、ジャガイモベーコン巻きをいただきま~す!】
具材の食感、塩味加減もちょうど良く、とてもおいしくいただきました。
おしまい!
と言いたいところですが・・・
「家に帰るまでが遠足」・・・
「後片付けまでが料理」です!
【ピカピカにして教室に帰っていきました!】
【大変よくできました!(ひよこちゃんより・・)】
~おしまい~
今日の給食&上学ニュース!(12/22)
【今日のメニュー】
〇麦ご飯、牛乳
〇厚揚げの中華煮
〇千切り大根のナムル
今日は冬至ですね!
1年間で最も昼が短く、夜が長い日です。冬至の日には、これからの本格的な冬の寒さに備え、栄養のあるかぼちゃを食べて健康を願い、ゆず湯で身を清める風習があります。また、「運盛り」といって、名前の終わりに「ん」がつくものを食べると縁起がいいとされています。
今日の給食で「ん」がつく食材は、さて何でしょう?
【千切りだいこん、にんじん、ごはん?】
縁起の良い食材を食べて、寒い冬を元気に過ごしましょう!
上学ニュース!
授業の様子の続きです!
1年生生活科「昔の遊び」です!
【お手玉に・・・】
【おはじきに・・】
【かるた取り・・・。すごい集中力を見せる1年生!】
【はいっ!!お見事!】
【こんなに上手にコマを回しているのは・・・】
【担任の先生です!この後・・・】
【手のひらの上で回します!大道芸人のような腕前にみんな感動!】
~番外編~
同じ日の昼休み・・・
【先生と5年生が一緒にけん玉練習中・・・】
先生が、熱心に教えていると思いきや・・・
【逆でした!「膝を使って」「脇を締めて」「持ち方は・・」etc・・。先生にアドバイスする少年。】
【本当にプロ級の腕前です!低学年の時に、以前いらっしゃった事務室の先生に教えていただいたのだそうです。いつか、お礼が言えるといいね!
】
授業の様子(12/21)
冬休み目前。授業の様子です。
中学部1年技術「木材加工」。
大工道具を巧みに操り、「本棚」制作中!
【トンチンカン、トンチンカン・・・】
【ゆ、ゆ、ゆび、気を付けて~!】
【グッジョブ!】
【個性あふれる作品が、次々と完成していました。】
【中学部3年生は、長縄8の字跳び挑戦中!】
【見よ!このジャンプ力!】
【男子は連続で300回くらいとんでいました!】
2月の縄跳び大会を楽しみにしています。
続いて小学部4年生。日本伝統の計算機・・・
【そろばんを使って計算中!】
【教え合いながら・・・】
【パチパチパチパチ・・・、知的な音が響いていました・・。】
~つづく~
小さな旅⑲(12/21)
小さな旅、PART19です!
【うれしそうに見せてくれたものは・・・】
【もう~い~くつね~ると~♫凧さんですね!お正月に空高く舞い上がらせましょう!】
クリスマス目前、小学部3年生の朝の歌・・・。
「ジングルベ~ル、ジングルベ~ル、すずが~なる~♫」
【ヘ~イ!】
サンタさんにも届くような元気いっぱいの歌声でした。
同じく今朝の光景。小学部5、6年生は、終業式で歌う校歌の練習中。
【6年生】
【5年生】
朝からきれいな歌声に癒やされました。
ここからは、昼休み・・
「先生、見てください!」
と職員室をのぞきながら言うので、行ってみると・・・
【おしりフリフリ、CMダンスを披露してくれました!】
【キマッタゼ!(もう、大笑いしました!)】
運動場では、理科の時間に作った、
【ペットボトルジャイロを・・・】
【それ~~~!(回転がかかり、驚くほど遠くへ飛んでいきました!)】
夢中で投げ続ける子ども達。これは、体育の遠投力強化にもつながりそうです!
~おしまい~
今日の給食&上学ニュース!(12/21)
【今日のメニュー】
〇セルフバーガーパン(タルタルソース)、牛乳
〇魚の南蛮、キャベツ
〇かぼちゃのポタージュ

今日の献立は・・・
【魚の南蛮バーガーです!】
甘酸っぱいタレに絡めた魚のフライとキャベツ、タルタルソースをパンではんさんでいただきます!
今日の魚は、なんと・・・
「フカ」・・。サメです!アカシュモクザメという種類だそうです。
あっさりしていて、南蛮だれともよく合って、とってもおいしかったです!
上学ニュース!
【毎朝のお楽しみ!児童・生徒会からの一言】
さて、12月21日、今日は何の日でしょう・・・?
【回文の日???上から読んでも、下から読んでもってやつですね!(12/21、なるほど!)】
「夜鳴くな犬寝場所なくなるよ」【お上手!】
「新聞紙」【王道!】
「やまもとやま?」【「上から読んでも山本山、下から読んでも山本山」この昭和を代表するCM、知っている子どもが、さて何人いるでしょうか!?】
相互参観授業⑦(12/20)
教師が授業を参観し合い、授業力を高めていく「相互参観授業」、最終回となりました。(全ての先生の授業を紹介できなかったのが残念ですが・・・)
中学部2年数学「図形の調べ方」の授業の様子です。
めあて「星形五角形の角の和の求め方を考えよう」
【まずは、自力解決を目指します・・・】
【試行錯誤中・・む、む、む、難しい・・・】
【ペア、そして、グループでこの難問可決を目指します!すると・・】
【ここに補助線を入れたら・・・】
【既習事項を使って・・・】
【わかった!180°だ!様々な方法で解答を導き出すことができました。】
現在、「目指すべき授業」としていわれている
主体的・対話的で深い学びのある授業を見させていただきました。
~相互参観授業「完」~
お弁当のおかずといえば・・・
昭和の時代、「巨人・大鵬・・・・」
そして、変わらずお弁当のおかず、人気NO.1といえば・・・
【玉子焼き!】
この玉子焼き作りに挑戦したのは・・・
【中学1年生です!】
【まずは、先生に見本を見せていただきます!】
【さすが!あっという間においしそうな玉子焼きの完成です!では、生徒のみなさん・・・】
【LET'S CHALLENGE!】
【なんかいい感じですよ~】
【さぁ、最終完成形はいかに・・・】
【ふわっふわの玉子焼きじゃないですか~!とってもおいしそう~!】
しかし、なかには・・・
【ドンマイ・・・次につなげよう!!】
では・・・
【いただきま~す!】
【おいしい顔ってこんな顔!(*^o^*)】
やはり、小学校から「弁当の日」で取り組んでいるからでしょう。(また、家でもやっているのでしょうね!)思った以上にレベルの高い玉子焼きが完成していてビックリしました!
~おしまい~
今日の給食&上学ニュース!(12/20)
【今日のメニュー】
〇麦ご飯、牛乳
〇宮崎牛カレー
〇ミックスビーンズサラダ

今日のメインディッシュは・・・

【宮崎牛カレーです!】
ご存じ内閣総理大臣賞を受賞した日本一のお肉です!
【こんなお肉が給食で食べられるなんて幸せですね!】
上学ニュース
座論梅の学習を続けてきた4年生。
今回は、これまでに梅について学習してきたことを・・・
【分かりやすくプレゼンを使って発表。その後は・・・】
【とってもおいしくできあがった梅ジュースを・・・】
【3年生にふるまいます!こういう先輩から後輩へと、絆を深める活動が多いことも、上学のとっても良いところだと思います。】
では3年生、いただきましょう!
【どうですかお味は???】
【うめ(梅)~~~!】
ようこそ!上学へ(新入児との交流会の巻)
先週木曜日に行われた、「新入児と1年生の交流会」の様子をお届けします。
【この日に向けて、一生懸命準備を進めてきた1年生・・・。しっかりおもてなしができたのでしょうか?】
【では、はじまり、はじまり~~~!】
【「的当てゲーム」「魚つりゲーム」「手作りの楽器」etc・・・。夢中になって遊ぶ新入児を温かな目で見つめる先輩達(1年生)。】
新入児のみなさん、上新田小には優しいお兄ちゃん、お姉ちゃんがたくさんいます。安心して入学してきてくださいね!
ハンドベルコンサート(IN MIKIFARM)
12月18日、日曜日。
前日の雨が嘘のような快晴の下・・・
ミキファーム ガーデンにおいて、本校ハンドベルクラブの演奏会が行われました。
このコンサートに向けて練習を重ねてきた曲は・・・「Jingle Bells」「over the Rainbow」「A Time for Joy」「Silent Night! Holy Night !」「Old MacDonald」「We Wish you a Merry Christmas」
なんと6曲も!
【素敵な音色が、寒かった会場を温かく包み込みます・・・。】
【お客さん&保護者の皆さん、うっとり・・・】
【先生達も、うっとり・・・】
【(演奏者の)5才の弟も、うっとり・・・】
【犬さんもうっとり!?】
今回は・・・
【新技?もたくさん披露してくれました!!】
屋外、寒さ、強風、たくさんのお客さんの前・・・、普段とかなり違う環境での演奏でしたが、練習は裏切りませんね。堂々とした素晴らしい演奏を披露してくれました。
ハンドベルクラブのみなさん、そして、指導してくださった先生方、素敵な1日を・・
【ありがとうございました!】
今日の給食(12/19)
【今日のメニュー】
〇減量コッペパン、牛乳
〇五目焼きそば
〇蒸しギョーザ

給食でよく登場するコッペパン。コッペパンの「コッペ」とは、小型フラスパンである「クーペ」が由来だそうですよ。
昭和の時代、ほぼ毎日登場していたコッペパンですが・・・(私が小学生の頃・・・)

【現在は、皮も生地もやわらかく、ふわふわ食感・・。ずいぶんおいしくなったものです。】
2学期も残り5日間となりました。
【給食着は回収するので、今週からエプロンでの給食当番です!】
給食をもりもり食べて、最後まで元気いっぱい過ごしましょう!
参観日特集⑤(激闘!クラスマッチの巻)
参観日特集最終回、「激闘!クラスマッチ!」編です!
競技は・・・
DODGE BALL!(ドッジボール)
優勝目指し、学年一丸となって競技に取り組んだ熱い戦い?!の様子をご覧ください。

【野球少年の剛速球が次々と炸裂!】

【「いけ~!」「にげろ~!」「まけるな~!」応援にも熱が入ります!】
【女子の戦いも白熱!】
【タイトル「絶体絶命!」】
【先生も大活躍!?そして・・】
【勝利の喜びを分かち合います!】
結果は、貫禄の総合優勝3年生!でしたが、どの学年もマラソン大会の疲れも見せず、全力でそして何より楽しそうにプレーしていたのが印象的でした。絆も深まったことでしょう!
生徒のみなさん、そして、楽しい企画をしてくださった先生方、大変お疲れ様でした!
~参観日特集「おしまい!」~
参観日特集④【学級懇談会編】
参観日特集、PART4。9月以来久しぶりに行われた学級懇談会の様子です。
【中学部の様子】
【小学部】
【6年生は、保護者同士会話が弾んでいました!】
小学部3年生・・・
【保護者が取り組んでいるのは・・・】
【子どもウォッチングテスト!普段、どのくらい、子どものことを見ているかこれで分かります・・・。】
例)「好きな教科」「好きな食べ物」「学校の遊び」「親に言われて嫌な言葉」「今1番欲しいもの」etc
さぁ結果は・・・?(前もって書いていた子どもの答えと比べます。)
【大変よくできました!子ども理解につながるよい取組ですね!】
担任の思い、保護者の思いをつなぐ、貴重な時間となりました。
~次回、最終回「中学部クラスマッチ編」です~
参観日特集③(持久走大会~番外編~)
【表彰式】
【持久走大会を振り返って(児童代表)】
けが人もなく、大盛況のうちに終えることができた持久走大会。
それでは、恒例の?!「番外編」をお届けします。
悲喜こもごも、ゴール後の様子をご覧ください。
【君たちは、元気やのぉ~・・。もう1回走る?】
~つづく~
次回・・
【学級懇談会&・・・】
【激闘!中学部クラスマッチの様子をお届けします!】
参観日特集②【小学部持久走大会編】
寒い中、たくさんの保護者の方々、地域の方々が見つめる中・・
【小学部持久走大会です!】
【校長先生の話:今年の漢字は「戦」。自分との戦いです!】
【「自分との戦い」を前に、集中する少年・・・。緊張感が伝わってきます!?】
【3,4年生スタート!】
【1、2年生アルアル・・、ロケットスタート!】
【5、6年スタート!】
【がんばれ~~!】
【おねえちゃん、がんばれ~~~~~~!】
そして・・・
【ゴ~~~ル!】
参観された保護者の方々は大きく頷かれると思います!
小学生もみんなよく頑張った!!
~次回「持久走大会~番外編~」お楽しみに~!~
参観日特集①【中学部持久走大会編】

お待たせしました!「参観日特集」。まずは、中学部の持久走大会からご覧ください。
【男子3km、女子2kmのスタートです!】
【この長い、長い下り坂を~♫一気に駆け下ります!】
行きは長い下り坂ということは・・・
【帰りは・・・、上学名物「心臓やぶりの坂」となります!】
【↑きついときこそ・・。そう笑顔です!がんばれ~~!】
さぁ、勝負の行方は・・・
【男子の部優勝!】
【女子の部優勝!速すぎて、ゴールテープが間に合わないハプニング・・・(カメラマンも・・)。ごめんなさい!】
【表彰式】
【持久走大会を振り返って:保体給食委員長より】
誰一人として、ふざけて走ったり、途中で諦めたりすることなく、自分の記録更新目指し全力で走り抜く姿に感動をもらいました。
選手の皆さん・・・
【大変お疲れ様でした!達成感あふれるVサイン!】
続いては・・・
小学部編です!お楽しみに~!
今日の給食&上学ニュース!(12/16)
【今日のメニュー】
〇麦ご飯、牛乳
〇新田原基地の日向夏風味からあげ、キャベツ
〇ざぶ汁

今日の小さいおかずは・・・
【新田原基地の日向夏風味空上げです!】
新田原基地では、日向夏を使った唐揚げを作り、給食に出しているそうです。からあげという字も航空自衛隊ということもあり、「空」に「上げる」と書いて「からあげ」と呼んでいるそうですよ。
上学っ子達も・・・
【未来に向かって、はばたきます!】
この後、参観日(持久走大会)特集です!お楽しみに!!
朝のあいさつ運動(12/16)
朝のあいさつ運動の様子をお伝えします。
前回のスペシャルゲスト・・・
ヴィアマテラスの皆さんに続き、今回は・・・
テゲバジャーロ宮崎と商工会の皆様です!
今回は、生徒会も参加しての「大あいさつ運動」
どんよりした曇り空を吹き飛ばすような元気なあいさつが上学にこだましました。
テゲバジャーロの皆様、そして商工会の皆様、寒い中、上学に元気を届けていただきありがとうございました。
テゲバジャーロの来シーズンの活躍、そして、J2昇格を願っています。
本日の持久走大会について
本日の持久走大会は、予定通り実施いたします。
よろしくお願いいたします。
今日の給食(12/15)
【今日のメニュー】
〇 麦ご飯、牛乳
〇 白菜のあんかけ丼
〇 ひじきの油炒め
【白菜のあんかけ丼】に使われている白菜は、
今が旬の冬を代表する野菜です!
そんな「白菜」にまつわるクイズです
白菜はどこの国で生まれた野菜でしょう?
① 中国 ② アメリカ ③ 日本
答えは①の中国です。
英語では、チャイニーズキャベツと呼ばれているそうですよ
寒くなるとやわらかくなり、甘みも出てきておいしくなります。
これからの季節には欠かせませんね
ぜひお子さんにも今日の給食の感想を聞かれてみてください
家庭教育学級視察研修(12/14)
12月14日(水)早朝・・・
【保護者の方々が続々と集まってきます!】
2学期は、子ども達の修学旅行(小6、中2)や宿泊学習(小5)など特集でお届けしてきましたが、今回は、保護者の修学旅行・・・?
【家庭教育学級視察研修です!】
まずは・・・
【高鍋農業高校にて・・・】
【牛さんとの交流です!優しくて、かわいい目に癒やされますね~!】
【みかん狩り体験。甘くておいしかったそうですよ!】
お昼は・・・
【安くて、おいしい~!高鍋農業高校寮の名物「赤弁」です。】
続いて向かったのは・・・
【ジャ、ジャ、ジャ、ジャージャ、ジャージャジャ~♫トップガンのテーマが流れてくるようです。航空自衛隊新田原基地到着!】
【F15のパイロット!?ではなく、T教頭です!】
「百聞は一見に如かず!」。寒い一日でしたが、貴重な体験をすることができたようです。
参加された保護者の皆様、大変お疲れ様でした。
相互参観授業⑥(中1 音楽)
相互参観授業PART6・・・。
【中学部1年生音楽。単元名は、ちょっと怖い・・・?「魔王」です!】
めあて「登場人物やピアノ伴奏の表現を聴き取り、曲全体の構成を理解することができる。」
【日本語バージョンとドイツ語バージョンを聞き比べます。】
【「魔王」の表現の工夫について・・・】
【「感じた雰囲気」「音の高さ」「強弱」「調(短調か長調か)」
「リズム」】
【班の代表者が発表】
「魔王」は、ドイツの作曲家、シューベルトの作品です。
高熱を出した息子を抱き、馬を飛ばす父親。「魔王がいる!」と叫ぶ息子をなだめる父親でしたが・・・。医者のもとに着くと、息子はすでに父親の腕の中で息絶えていたという、悲しいお話です。
生徒達は、詳しい話の内容は知らなくても、曲の感じを敏感につかみ、作者の意図した表現の工夫に気付くことができました。
~相互参観授業「つづく」~
今日の給食&上学ニュース!(12/14)
小さな旅の続きから・・・
中学部保健室前に、1年生が訪問中。
養護教諭の先生に教えてもらっているのは・・・
【そうじの後、水洗いだけでは、こんなにウィルスが付着しています。しかし・・】
【石けんをつけて「ハッピバースディ」の曲2回分手洗い+消毒すると、こんなにきれいに!】
とっても分かりやすい掲示物のおかげで、上学っ子、みんなきれいに手洗い、消毒をしています。
ということで・・・
【きれいになった手で、今から給食いただきます!】
(今日のメニュー)
〇黒糖パン、牛乳
〇さつまいものクリーム煮
〇ズッキーニのサラダ
今日は、新富町地産地消の日です。
【クリーム煮のさつまいもと、サラダの「きゅうり」と「ズッキーニ」です。】
【どれがきゅうりで、どれがズッキーニか分かりますか?】
地元の安心、安全でおいしい食材に感謝して、いただきます!!
上学ニュース!
ハンドベルクラブの子ども達、現在「クリスマスコンサート」に向け、毎日昼休みに練習中です!
【校内クリスマスコンサート】
〇12月15日(木) 8:10~ 体育館にて
【ミキファームクリスマスイベント】
〇12月18日(日) 10:00予定 ミキファームガーデン
小さな旅⑱
上学の何気ない日常をお伝えする「小さな旅」
師走の慌ただしい日々でお疲れのみなさん、しばし、癒やしの時間をお過ごしください。
先日、ジャガイモの種芋を植えた小学部2年生・・・
【ずいぶん大きくなりましたね!3学期、収穫するのが楽しみになってきました。】
【休み時間、手品を見せてくれるという少年。机の上に置いてある紙を手を触れずに・・・】
【ヤー!!・・・・・・。なんと・・・倒れない。残念!また挑戦してね~!】
昼休み、すこし縄跳びに飽きた子ども達・・・
【笑顔で電車ごっこ!縄跳びあるあるです!】
同じく昼休み
【何やら職員室が盛り上がっています!】
【中学生が、ペープサートを使っての英語音読劇を披露中】
【一生懸命練習したのでしょう。流ちょうな英語ととってもかわいい人形の動きに・・・】
【先生方も大喜び!大きな拍手が送られました!】
【上学英語人形劇一座!?の皆さん・・。次回の講演も楽しみにしていま~す!】
~つづく~
持久走大会、雨天時の対応について(12/13)
金曜日、少し天気が心配になってきました。
持久走大会、無事実施できることを願いつつ、「雨天時の対応」についての文書を出しています。(sigfyにて)
ご確認ください。
今日の給食&上学ニュース!(12/13)
【今日のメニュー】
〇麦ご飯、牛乳
〇いり鶏
〇三色和え
昨日は、イギリスのエリザベス2世が食した洋食でしたが・・。
今日は・・・
【いり鶏に・・】
【三色和えと、完全和食です!】
洋食に和食、中華・・・、各国の食文化も考え、いつもおいしい給食を提供していただいている給食センターの皆様、ありがとうございます!
「和食」は、2013年に、世界無形文化遺産に登録された素晴らしい日本文化です。肉よりも野菜が多く、野菜や豆をよく使いとても健康的です!(私は、和食が大好きです!)
上学ニュース!
月に1度のお楽しみ!
今年最後の読み聞かせ交流会が行われました。
【今回もワクワクするような楽しい絵本ばかり・・・】
【サンタクロースが登場するお話も。子ども達は当然・・・】
【にこにこ笑顔に・・・】
【どんどん前のめり・・・】
【中学生も・・・】
【絵本の世界に浸っています。】
↓今回読んでいただいた絵本です。(一部です)
今回も、子ども達の心を耕し、たくさんの栄養を注いでいただきました。
読み聞かせボランティア「赤ずきん」の皆様、読み聞かせ委員の皆様、誠にありがとうございました。
次回、1月17日(火)も楽しみにしています。
相互参観授業⑤
小学部1年生算数「ものとひとのかず」の授業です。
めあて「のこりのまいすうの もとめかたをかんがえよう」
ちょっと難しい文章問題です。大丈夫かなぁ・・・
【まずは、文章を指で押さえながら、正確に読んでいきます。】
【さぁ、自力で解けるかな?】
【お見事!それにしてもみんな、ノートのまとめ方が美しい!(とても1年生とは思えません!)】
【姿勢も立派です!パチパチパチ・・・】
まとめは・・・
学習のまとめの後は・・・
【先生から送られてきた問題に挑戦です!】
【時間いっぱい、様々な問題に取り組み、しっかりと内容が身に付きました。】
学力を支える、「話す」「聞く」「読む」「書く」等の技能がしっかりと身に付いてきている1年生、これからさらに伸びていくことでしょう!
相互参観授業④
相互参観授業、PART4。
まずは、小学部6年生算数「わくわく算数ひろば 算数ラボ」の授業からです。
めあて「倍数を見つけるプログラムは、どのようにつくればよいのだろうか」(いわゆるプログラミング教育の授業です。)
【まずは、人力で2の倍数に色を塗っていきます。結構大変な作業ですね!】
【次に、コンピュータにプログラミングしていきます。どのように入力すればいいのでしょうか!?】
【条件「ますの数が2で割りきれるならばますを赤で塗る」→「1ます進む」・・・。一つ一つ条件を入力。】
一つ一つ、コンピュータの気持ち!?になって入力していけば・・・
【なんて簡単に作業してくれるんだ!】
「お~~~!」子ども達からも驚きの声が上がっていました。

【どんな条件を入力したのか発表し合い、共有していきます。】
この時間のまとめ「倍数を見つけるプログラムは、倍数の性質から命令の順番を決めて組み合わせてつくればよい」
* プログラミング教育は、情報活用能力を育成する教育の一つで、小中高全ての学校において、行っていきます。小学校では、算数、理科、家庭科が中心になります。
~相互参観授業「つづく」~
心と体を解き放て!
「心と体を解き放て!」
「中学部ダンス講習会」の様子です。昨年度に引き続き、今年も来ていただきました!
【ダンスカンパニー「んまつーポス」(スポーツマンの反対読み)の皆様です!】
では、生徒達が、心も体も解き放ち、笑顔でダンスを楽しんでいる様子をご覧ください。
【まずは、アイスブレーキング。恥ずかしさを取り除いていきます。そして、徐々に・・・】
【チームで動きを合わせていきます。】
【だんだん速く、激しく!さぁ、生徒達、ついていけるのか?!】
【いいよ~~!】
【すてき~~!】
【とってもいいよ~~!(ヘビメタ少年登場!)(動きが速すぎてピントが合わない・・。)】
最後には・・・
【この状態・・・。ねぇ!どうだった今回のダンスは???】
【ブラボ~~!!】
思いっきり動く楽しさ、動きを工夫する楽しさ、動きをつくり出す楽しさをたっぷり体験させていただきました。
んまつーポスの皆様、誠にありがとうございました。
*今日は、中学部3年生の講習会が予定されています。
今日の給食&上学ニュース!(12/12)
【今日のメニュー】
〇ミルクパン、牛乳
〇肉団子スープ
〇コロネーションサラダ

コロネーションサラダって何??
説明します
今から約70年前、イギリスのエリザベス2世が女王になる式典の際、考えられ、出された料理が「コロネーションチキン」だそうです。
コロネーションチキンは、ゆでた鶏肉をマヨネーズ、カレー粉、ジャムなどで和えた料理です。
今日は、この式典で出されたチキンを・・

【サラダにして提供です!】
【エリザベス2世になった気分?】
上学ニュース
来たる持久走大会に向け、小学部、中学部ともに試走を行いました。
小学部の様子をお届けします
小学部3~6年生は、運動場だけでなく校外も走るので・・・
【コースのポイントごとに、気を付けることを説明】
この後、いよいよ・・・
【全力試走です!】
本番での目標は、自己記録更新です!そのために、体育の時間以外でも・・・
【今年は、意欲的に練習している光景をよく目にします。(↑写真は昼休みの様子)】
走った後・・・
【小3~小6は・・・】
【5周ごとにシールを貼っていきます!もう、こんなにたくさんのシールが!】
そして、初めての持久走大会の小学部1年生は・・・
【マラソンカードにチャレンジ中!もう半分まで来ていますね!】
それでは、本日12月12日ということで・・・
【1・2,1・2・・・。これからも目標に向かって、マイペースで走っていきましょう!】
120万アクセス突破!(12/11)
12月11日(土)夜、本校ホームページアクセス数が、120万を突破しました。11月27日に110万を突破してから、14日間での達成となりました。1日平均にすると、7142人の方にアクセスしていただいた計算になります。
毎日、たくさんの方々にお立ち寄りいただき、誠にありがとうございます。
今日の給食(12/9)
【今日のメニュー】
〇 赤かぶ青菜ご飯、牛乳
〇 うどんすき
〇 なます
【なます】は、人参と大根が使われており、これは紅白の水引を表現したもので、縁起物とされています。
2学期も残り2週間となりました。縁起のよいなますを食べて、元気に楽しく過ごしていきたいですね
上学ギャラリー(12/9)
【これ、ぼくの作品です!】
「しんとみ生涯学習ウィーク作品展示会」に出品していた作品が戻ってきました。
子ども達の力作をご覧ください。まずは、中学部から・・・
【↑ 教育長賞受賞作品】
続いて小学部・・・
参観日まで展示されています。ぜひ、ご覧になってください。
授業の様子(12/8)
授業の様子をお届けします
まずは、小学部1年生。
【(先日HPでお伝えした)図工で作ったごちそうの・・・】
【ミニ撮影会!角度、明かりを試行錯誤しながら・・・】
【タブレットでパシャッ、パシャッ・・】
【ごちそうも笑顔も輝いています!】
続いては・・・
【中学部1年生理科「音の現象」です。】
【グラスに水を入れて・・・】
【指でこすると・・・。あ~ら不思議!優しい高音が響きます。】
【確かに聞こえます!】
音は、空気中で振動することによって伝わるのだから・・・
めあて「空気がなければ音は伝わらないのだろうか?」
【やってみようじゃありませんか!!】
【目覚まし時計のブザーを鳴らしながら・・・】
【一生懸命、ポンプで空気を抜くと・・・】
【「し~~~~~、静かに!」・・・音が消えた!】
空気中(65.3)空気を抜くと(40.0)
結論「空気がないところでは、音は伝わらない」
では、宇宙では?!興味がどんどん広がっていきます!
やはり、「理科は感動!」ですね。
~おしまい~
今日の給食&上学ニュース!(12/8)
【今日のメニュー】
〇麦ご飯、牛乳
〇魚の竜田揚げ、ゆでもやし
〇いもっこ汁

上学ニュース!
小学部6年生、思い出いっぱいの修学旅行・・・
【記憶だけでなく・・・】
【活字として残るように新聞にまとめました!では、中身を見てみましょう!】
【見出し、レイアウト、写真、文章内容、どれも小学生とは思えないできばえです!】
【これまでの学習の中で、一人一台タブレットを積極的に活用し、スキルアップしてきているのがよく分かります。】
相互参観授業③
教師、一人一人の授業力向上を目指す「相互参観授業」PART3です。
【こんなにアクティブに学習に取り組んでいるのは・・・】
【小学部3年生外国語活動「This Is for you. カードを送ろう」】
めあて「欲しいものを進んで伝えて形を集め、カードを作ろう。」
【少年A「What do you want?」少女B「A blue triangle please.」(いわゆる「お店屋さんごっこ」をしながら、この表現に慣れていきます。)】
【アダム先生のお店屋さんにも LET'S GO!!ネイティブ イングリッシュにふれる良い機会です。】
【役になりきってショッピングを楽しむ少年・・・。ちなみにおじいさん役です!】
本当に外国語活動が大好きな3年生です。
続いて・・・
【中学部1年生国語「いにしえの心にふれる(縫采の玉の枝ー「竹取物語」から)」】
【めあて「古典の文章と現代の文章の違いを確かめよう」】
【知っている古典を相談中・・・。万葉集に源氏物語、枕草子・・。そして今回学習するのは・・】
【竹取物語。そう「かぐや姫」です。生徒は、小学5年生の時に暗唱にチャレンジしたとかで・・・】
【スラスラと読み切る生徒達。では・・・】
【現代文と古典の違いは???】
【タブレットに入力して提出!】
一人で、ペアで・・、様々な音読を取り入れたことで、生徒は、スムーズに古典の世界に入り込むことができました。
~PART4へ「つづく」~
今日の給食&上学ニュース!(12/7)
【今日のメニュー】
〇米粉パン、牛乳
〇チリコンカン
〇千切り大根のゴマネーズサラダ

今日のサラダは・・・

【千切り大根のゴマネーズサラダ】
千切り大根は、ご存じのように長期間保存が可能な上に、食物繊維等の栄養もたっぷり!という実に優秀な食材です!
そういえば・・・
中学部3年生・・・。(11/10)
さつまいもの収穫が無事終わり、新たにお世話し始めた野菜が、
【もうお分かりですね!?】
【大根です!(本日)1ヶ月でこんなに大きく成長しました。】
収穫したら、千切り大根にするそうです。また、楽しみが増えましたね!
【小学部の大根は???】
【もう収穫間近です!】
上学ニュース!
今日は・・
【クリスマスツリーの日!だそうです。(全く知りませんでした。)】
1886年(明治19年)のこの日、横浜「明治屋」に日本初のクリスマスツリーが飾られたのだそうです。
ということでこの後、学校で見つけたクリスマス特集(ラストクリスマス♫の曲でも口ずさみながら・・)ご覧ください!
【まずは図書館。至る所にクリスマスの雰囲気が・・】
【サンタさんも笑顔で登場です!】
各教室にも・・
【至る所に、クリスマスの飾りや絵が・・】
そして・・・
【子ども達のファッションにも・・・】
【とっても、似合っているよ!(クリスマスが終わっても、また着て来てね!
)】
小さな旅⑰(12/7)
小さな旅、PART17です!
【1,2年生のお楽しみ、折り紙・・・。どのくらい上達したのかな?】
【おじょうず~~!(うれしそうに見せてくれました!)】
【完成品のレベル高っ!!】
【癒やされますねぇ~。】
運動場では・・・
【小学部3年生が、何やらゴソゴソ作業中。覗いてみると・・、】
【図工で作ったものを自然の中にとけ込ませています。これはメルヘン!!】
【木の妖精みたい・・・】
【こ、この妖精は、ちょっと怖い・・】
中学部3年生は・・・
【楽しかった「さつまいも収穫祭」の後・・・】
【残ったおいもを・・・】
【干し芋にします!(さすが!一切れも無駄にはいたしません!)】
時は過ぎ、1週間後・・・
【完成です!お味は???】
【実に美味!甘くて、本当においしかったです!】
~小さな旅⑰「おしまい!」~
おもちゃランドへようこそ!
小学部1、2年生がとっても楽しみにしていた大イベント、「おもちゃランドへようこそ」が先週行われました。
昨年は・・・
【3年生(現)に招待され、思いっきり楽しんだ2年生(現)(↑昨年度の様子より)】
1年後・・
【一回り大きく成長したお兄ちゃん、お姉ちゃんとなって、1年生をご招待です!】
【クレーンゲームに的当て、くじ引き、魚つりゲームetc、豪華景品もた~くさん!】
【この日のために、2年生みんなで協力して準備してきた、素敵なおもちゃばかりです。】
【先輩達のおかげで、思いっきり楽しむことのできた1年生でした・・・。(このご恩は、来年の1年生に返すことでしょう!)】
【優しくて、頼りがいのある2年生、ありがとうございました!】
これまで以上に、仲良くなった1,2年生でした。
~おしまい~
今日の給食(12/6)
【今日のメニュー】
〇麦ご飯、牛乳
〇豚肉のちゃんちゃん焼き
〇つくねだんご汁

今日の小さいおかずは・・・
【「ちゃんちゃん焼き」です!かわいいお名前ですね!】
「ちゃんちゃん焼き」は、鮭(今日は豚肉)などの魚とキャベツや玉ねぎ、もやしなどの野菜を焼いて、味噌で味付けした北海道の郷土料理だそうです。
では、ナイスなネーミング、「ちゃんちゃん焼き」の由来は何だと思いますか?
① 父ちゃんが作るから
② ちゃっちゃと作れるから
③ 焼くときに鉄板がチャンチャンと音を立てるから
正解は、分かりません・・・
それぞれの説があるそうですよ!(すみません・・)
野菜がたくさん入っていて栄養満点ですね!
上学ニュース!
この話題をお伝えするのも最後になってしまいました・・・
【残念ながらPK戦で敗れる。初のベスト8ならず・・・】
でも、大きな夢を見させてくれたサムライブルーの選手たちには感謝です!(大のサッカーファンのKK先生もそう言っています!)
落胆しているみなさん・・・
【この子達を見て元気を出してください!】
【この冬1番の寒さにも負けず半袖で登校!】
【ブラボー!!】(でも、無理して風邪ひかないでね・・
)
持久走大会に向けて・・・
12月16日(金)の持久走大会に向けて、練習にも熱が入ってきました。
【中学部は、まず、脈拍数をはかり、自分の体の状態を確認します。】
* 成人の1分間の心拍数は、60~100ですが、シドニーオリンピック金メダリストの高橋尚子選手は、全盛期36/1分間だったそうですよ。すごいですねぇ!
【12分間走スタート!】
【自分に合ったペースで走り抜きます。走った後は・・】
【この状態・・・。全力でがんばった証拠ですね!】
【走った後も脈をはかり、体にどのくらいの負荷がかかったのか確認していきます。】
アテネオリンピック、マラソン金メダリストの野口みずき選手は言っています。
「走った距離は裏切らない」
体力向上はもちろんですが、目標に向かって努力する力、つらいことから逃げず、立ち向かっていく力を伸ばして欲しいと思います。
12月16日(金)上学持久走大会号砲です!
万障お繰り合わせの上、たくさんの方々の参観(応援)をお待ちしております。
今日の給食&上学ニュース!(12/5)
【今日のメニュー】
〇減量コッペパン、牛乳
〇ペペロンチーノ
〇ブロッコリーサラダ
〇焼きプリンタルト
今日は、富田中3年生のリクエスト献立です。
では、今日のメニューの中で、リクエスト断トツ1位だったものは何でしょう?
【ペペロンチーノだそうです!小学部ならきっとこれでしょう!】
【焼きプリンタルト!】
1月は、新田中3年生のリクエスト献立だそうです!
楽しみにしています!
上学ニュース!
12月1日(木)から10日(土)まで、「冬の交通安全県民総ぐるみ運動」が行われています。
本校でも・・・
【交通安全クイズ特設コーナーを設置しました。】
【「自転車は道路の右側を走っていいですか?」問題をめくってみると・・・】
【正解は、「左側です!」】
子ども達は、楽しみながら、継続して交通安全について学んでいます。
これをご覧のドライバーの皆様、師走の慌ただしい時期ですが、安全運転を心がけていきましょう。
上学ギャラリー(12/5)
10月19日(水)に、小学部4年生が、運動場を歩き回り、拾い集めていた小枝や落ち葉・・・
【加工、装飾を加え、ついに・・・】
【完成です!】
作品タイトル「ひみつのすみか」。じっくりご覧ください!
【タイトル「メラメラのひみつきち」】
【タイトル「メルヘンハウス」】
【タイトル「理想の部屋」】
【細かいところにも工夫がいっぱい!】
子ども達が想像力をフル稼働させ作り上げた、見応えのある作品ばかりです。なにより、夢中になって、目を輝かせながら作っていたのが印象的でした。
ぜひ、12月16日の参観日でゆっくりご覧になってください。
新聞掲載のお知らせ(12/3)
12月3日(土)付、宮日こども新聞「学園歌壇」コーナーに、4年生黒木 葵唯さんの作品が掲載されました。
おめでとうございます!
【掲載作品】
ささの葉にたんざくかざってねがいごと キラキラかがやくきれいな天の川
相互参観授業②
「行う!見る!語り合う」をテーマに、お互いの授業を参観し、評価し、高め合っていく「相互参観授業」。PART2です。
ダイジェストでお届けします!
【小学部3年理科「電気で明かりを付けよう」】
めあて「明かりをつけるには何が必要か?」
【班で話し合いながら・・・】
【どうやったら明かりがつくのか、予想を考え、タブレットから提出します。】
中学部3年生英語「Is AI Friend or an Enemy?」
【めあて「(教科書に出てくる)AIにできることは何だろう?」
中学部3年国語「いにしえの心を受け継ぐ」
小学部2年体育「ボールゲーム」
【めあて「守るときのコツをつかもう」】
【アタ~~ック!】
~相互参観授業PART3へ「つづく」~
今日の給食(12/2)
【今日のメニュー】
〇麦ご飯、牛乳
〇ほうとう汁
〇きんぴられんこん

ほうとう汁は、山梨県を中心とした地域で作られる郷土料理です。使う麺は、うどんと違って、寝かさずにすぐに切って煮込むため、煮くずれしやすく、汁にとろみがつきます。
麺と味噌がまじりあい・・・
【ほうとう(本当)おいしかったです!)
さて、今朝の上学は、W杯サッカーの話題で持ちきりです。
職員室のホワイトボードには・・・
【K先生からの熱いメッセージが!】
そして、もちろん・・・!?
【生徒会長からも・・・】
【12月5日(月)のクロアチア戦で、また盛り上がりそうです!】
初のベスト8!目指し、がんばれニッポン!!
ふるさと上新田地域探索学習(中1)
中学部1年生が、先日の「農業体験学習」に引き続き取り組んでいる、「ふるさと上新田地域探索学習」の様子をお届けします。

【事前学習会で、前知識を得た生徒達・・・】
【12月1日(木)、いよいよ、地域に飛び出していきます!】
【がんばります!】
た~くさんの場所を見学しました。ダイジェストでお届けします。
【春日地区のいちょう】
【春日神社】
【百足塚古墳】
【一丁田池】
【座論梅】
【総合交流センター「キラリ」】
【岩脇の化石層群】
【湖水ヶ池】
【富田浜】
【いい波ですねぇ~!】
【童心にかえって砂遊び】
計9か所!ふるさとの宝をしっかりと目に焼き付けることのできた生徒達です。
お忙しい中帯同していただき、詳しく説明していただいた桑村様、
【ありがとうございました!】
おいも祭り!②(実食!)
中学部3年生「おいも祭り!」いよいよ実食です!はじける笑顔をご覧ください!
【いや~、うまいっす!!(光GENJI!?)】
受験勉強で大変な中学3年生。いいストレス解消になりましたね!
【番外編】
【遊び心も忘れない子ども達・・・】
【カメラマンにもくれるの???】
【ありがとう~~~!明るくて、優しくて、面白い3年生、だ~~い好き!】
~おいも祭り!「おしまい!」~
おいも祭り!!(12/1)
本日、楽しい体験活動が目白押し!
中学部3年生が、10月13日、に収穫したさつまいも。
いよいよ本日・・・
【収穫祭です!】
生徒自らメニューを選び、材料を買い、準備してきました。
さぁ、どんなさつまいも料理ができあがったのでしょうか?
【何を作っているのか予想しながらご覧ください!】
【「さつまいも餅」「さつまいもパイ」「さつまいもプリン」「さつまいもチップス」etc・・】
時々・・・
【味見?つまみ食い?】
【誰だ!?犯人は!】
【先生達も楽しそう・・・】
この後、お待ちかね実食です!!
~つづく~
今日の給食&上学ニュース!(12/1)
【今日のメニュー】
〇麦ご飯、牛乳
〇肉じゃが
〇納豆サラダ

今日の小さいおかずは、上新田小6年生のリクエスト献立でも人気があった・・・
【納豆サラダです!】
苦手な人もいるかもしれませんが・・・(実は・・・)
納豆にはたんぱく質やカルシウム、食物繊維が多く含まれていて、栄養満点です!がんばって完食しましょう!
(はいっ、がんばります!)
上学ニュース!
中学部2年生は、今日と明日・・・
小学部5年生は、本日、「みやざき小中学校学習状況調査」が行われています。
【日頃の学習の成果を発揮すべく、時間いっぱい真剣に取り組んでいます!】
小さな旅⑯(12/1)
早いものでもう12月ですねぇ・・
今回の「小さな旅」は、年末の雰囲気が漂ってきた上学編です。
【5、6年生教室前のクリスマスリース】
【あいさつの木もクリスマスツリーに・・・】
【小学部が朝、歌う曲も・・・】
【♫ジングルベル、ジングルベル、すずがなる~♫】
【運動場では・・・】
【イチョウの木も衣替え・・】
急に寒くもなってきましたね。でも・・・
【昼休み、元気に遊ぶ子ども達・・・。】
【1年生サッカーあるある・・。】
【ボールと一緒に大移動!!】
~つづく~
相互参観授業①
教師一人一人の授業力向上を目指し、お互いの授業を参観し、評価し合う、「相互参観授業」。
今年度2回目がスタートしています。
【事前研修会の様子】
【小・中学部の教師がチームを作り、切磋琢磨していきます。】
では、授業の様子をご覧ください。
【小学部4年生「県の伝統・文化と先人のはたらき」】
めあて「地域の発展に、どんなことで貢献したのか調べよう。」
【宮崎の偉人について、タブレットを活用して調べていきます。】
【調べたことはワークシートに記入】
【まとめは、子ども達と一緒に考えていきます。】
子ども達が意欲的に調べ、話し合う姿がとても印象的でした。
*「相互参観授業」、これから特集でお届けしていきます。
今日の給食(11/30)
【今日のメニュー】
〇チーズパン、牛乳
〇かぼちゃコロッケ、ブロッコリー
〇ポトフ

食べ物クイズです!かぼちゃの旬の時期はいつでしょう?
①夏 ②秋 ③冬
答えは、①です。ハロウィンで活躍するから②と思いませんでしたか?
かぼちゃは、日持ちするため貯蔵して甘みが増したものを寒い時期に食べると、風邪予防に良いと言われています。
しっかり食べて、寒い冬を元気に過ごしましょう!
第24回西都・児湯の子どもたちによる絵画展入選者
「第24回西都・児湯の子どもたちによる絵画展」において、本校児童生徒が素晴らしい成績を収めています。
*西都児湯で、各学年金賞1名、銀賞2名、銅賞3名です。
【金賞】
〇 小学6年 岩切 凜音さん
〇 中学2年 永野 芽生さん
〇 中学3年 祝迫 実樹さん
【銀賞】
〇 小学1年 岩元 奏大さん
〇 小学4年 黒木 葵唯さん
〇 小学5年 飯干 姫成さん
【銅賞】
〇 小学3年 和田 明凛さん
〇 中学1年 児玉 奈桜さん
おめでとうございます!
1129の日特集③【給食編】
宮崎牛祭り!続きます!
給食のメインディッシュ・・
【ハヤシライスの中には・・】
【たっぷりの宮崎牛が!!】
(今日のメニュー)
〇麦ご飯、牛乳
〇ハヤシライス
〇ツナサラダ
以上!1129の日特集「お・し・ま・い!」
ひょっとして、晩ご飯にも・・・
【宮崎牛登場!あるかも・・?】
1129の日特集②

お待ちかね実食です!
【感謝して、「いただきます!」】
【モモ肉と肩ロースを食べ比べます!どちらもおいしそう・・】
【やわらかっ!!】
【肉汁ジュースがあふれてきます!】
【う・ま~べらす!!】
この教室をとおして、宮崎の誇り「宮崎牛」をよく知り、もっともっと大好きになった子ども達でした。
今回の教室を開いていただいた関係者の皆様、貴重な体験を子ども達に提供していただき、誠にありがとうございました。
1129の日特集、まだ終わりません!
何と!今日の給食にも・・
【宮崎牛登場!です!】
1129の日特集①
今日は11月29日(火)、ご存じ・・・
「いい肉の日」です!
だから、というわけではありませんが、偶然にも本日、宮崎牛について学習する・・・
【モーモー教室が開かれました。(小学部5、6年生参加)】
【講師に、「より良き宮崎牛づくり対策協議会」「JA」「経済連」「生産者」の皆様に来ていただきました。】
【「宮崎牛とは・・」「宮崎牛おいしさの秘密・・」「生産者の苦労や喜び・・」等たくさんのことを分かりやすく教えていただきました。】
【一生懸命メモを取ったり、積極的に質問をしたりする子ども達・・。それに対して・・。】
【丁寧に答えていただきました。】
やはり1番大切にして欲しいことは・・・
【命に感謝して「いただきます」、残さず食べて「ごちそうさま」】
宮崎牛に対する知識、生産者の思い等、たくさん学ぶことができた子ども達。この後、いよいよ、4大会連続内閣総理大臣賞を受賞した日本一のお肉を・・・
【いただきます!!】
~つづく~
110万アクセス突破!
11月28日(月)夜、本校ホームページアクセス数が、110万を突破しました。
11月17日(木)に、100万アクセスを達成してから、わずか11日での到達です。この間、1日の平均アクセス数は、9000を超えています。
毎日たくさんの方にお立ち寄りいただき、感謝申し上げます。
授業の様子(11/28)
お伝えすることができていなかった授業の様子をお届けします。
【1年生図工「ごちそうパーティをしよう」】
さぁ、どんなごちそうを作ってくれたのでしょうか?
【紙粘土を使って・・・】
【自分にとっての最高のごちそうを表現・・】
【うれしそうに見せてくれた少年。ごちそうといえばやっぱり・・】
【お寿司ですよねぇ~!】
これに色づけをし、ニスを塗ると・・・
【ごちそうパーティ会場のできあがり!】
【どれも、ショーウィンドウの食品サンプルのようにきれいですね!】
続いては・・
【アスリート揃いの2年生、鉄棒の授業です。】
【逆上がりに・・】
【足かけ前まわり・・・】
そして、大技・・
【コウモリのようにぶら下がり、体を揺らして・・・】
【ジャ~ンプ!!見事着地!かっこいい~~!】
一人一人、自分のめあての技に一生懸命チャレンジしている姿が印象的でした。
~つづく~
今日の給食&上学ニュース!(11/27)
【今日のメニュー】
〇コッペパン、牛乳
〇コーンラーメン
〇枝豆サラダ
W杯、日本痛恨の黒星で、ブルーマンデーです。
でも、今日の給食の・・・
【食欲をそそるコーンラーメンのにおいとチャンポンなみの具だくさん。そして・・・】
【大好物の枝豆の入ったサラダに元気をもらいました!さらに・・】
【ラッキーきゅうり発見!何かいいことありそうな・・】
【ありました!】
【5年生からお米のプレゼント!】
ありがとうございました!
*12/2(金),スペイン戦。決勝トーナメント進出目指し、がんばれ!ニッポン!!
上学ニュース!
11月22日(火)、火災避難訓練を行いました。
【ジリリリリリ・・・!火災報知器が鳴り響きます。「小学部理科室から火災発生」】
【避難の合言葉「お(押さない)は(走らない)し(しゃべらない)も(もどらない)」を意識して避難中】
避難するまでにかかった時間は?(昨年度3分39秒でしたが・・)
【3分26秒!!】
1秒でも早く避難することが求められますが、13秒も早く避難することができました。一人一人の危険回避への意識が高まってきているからだと思います。
【東児湯消防組合分遣所の方のお話。「火災時の避難の仕方について」「消火器の使い方について」】
【水消化器体験】
子ども達は、訓練に真剣に取り組む中で、「自分の命は自分で守る」ための方法を学び、体験することができました。
非常時の避難については、ぜひ、ご家庭でも話し合われてください。
忘れてならないことは・・・
「災害は忘れたころにやってくる」
です。
ご飯とみそ汁(小5)
【稲刈りの様子(9/22)】
5年生が、総合的な学習の時間に取り組んできた「お米学習」、いよいよクライマックス・・・
【収穫したお米をいただきます!家庭科「ご飯とみそ汁」の授業です。】
【お鍋でご飯を炊いていきます。大切なお米を無駄にできない!と真剣勝負の子ども達】
【初めちょろちょろ、中ぱっぱ、赤子が泣いてもふた取るな!(子ども達は知らないかなぁ・・)】
一方みそ汁は・・・
【いい感じですねぇ~!おいしい匂いが漂ってきました。】
それでは・・
【実食!】
【ちょっ、ちょっと!?やわいけど・・・】
【どう???】
【おいしいで~~す!】
この「お米学習」をとおして、農家の方の苦労や収穫の喜び、食への感謝等、多くのことを学ぶことができた5年生です。
~おしまい~
作文がラジオで放送されます!(11/28)
11月28日(本日)、児童の作文が、MRTラジオ「私たちの作文」で放送されます。
〇 小学部6年生 中武 旺雅さん 題名「県大会で全力プレー」
〇 16:50から(再放送 12/5 午前5:00から)
修学旅行特集~最終回~(帰校式)
修学旅行特集、最終回!
【おかえりなさ~~~い!】
【帰校式】
【児童代表報告:充実した旅行だったことがよく伝わる発表でした。】
2日間、しっかり学び、体験し、遊び、友情を深めることのできた素晴らしい修学旅行となったようです。さすが上学の6年生です!
さらにレベルアップした子ども達、これからの学校生活で、その成果を見せてくれることを楽しみにしています。
帰校式の後・・・
【久しぶりの親子の再会!】
【会いたかったよ~~!】
~修学旅行特集[FIN]~
たくさんのご視聴ありがとうございました!
修学旅行特集⑪(バスの中では・・・)
次回最終回とお伝えしましたが・・・
バスの中では、宅習パス券(宅習免除)をかけた・・・
【真剣勝負のビンゴ大会が行われているようです!】
【先生のマイクパフォーマンスで、盛り上がりは最高潮!】
【リーチ!】
最後まで旅を満喫している子ども達です。
到着予定ですが、20分早まって、17:30予定です。
修学旅行特集⑩(昼食編)
早いもので修学旅行も終盤、最後のお食事です。(桜見亭にて)
メニューは・・・
【鶏飯、冷しゃぶ、うどん、さつま揚げです。】
上学ご一行、すでに帰路についています。
帰校は、今のところ、予定通り17時50分くらいです。
~次回いよいよ、最終回です!~
修学旅行特集⑨(知覧特攻平和会館)
最後の見学地、「知覧特攻平和会館」での学習の様子です。
【「とこしへに」特攻像前にて・・・】
国を思い、父母を思い、永遠の平和を願いながら、飛び立っていったことでしょう。
【零戦の前にて・・】
【語り部さんの講話】
【戦争で犠牲になった方の魂が安らかであること、世界が平和になってくれることを願い・・・】
【千羽鶴の奉納】
~つづく~
この後、昼食です!
修学旅行特集⑨(平川動物園)
子ども達が最も楽しみにしていた場所・・・
【平川動物園到着です!】
青空の下、笑顔いっぱいの子ども達の様子をご覧ください!
【早速コアラ館へ・・】
【コアラのかわいさに癒やされる子ども達・・。(僕もコアラになりたいなぁ)】
【ペンギンさんと記念撮影】
【後ろにいる動物、なんて言うんだったけ???】
【飼育員さんに、積極的に質問する子ども達】
続いて遊園地へ・・
【「競走か!負けないぞ!」】
【おみやげもいっぱい買いましたね!】
【朝食あんなに食べたのに、まだ食べるの?】
~つづく~
次回、「知覧特攻平和会館」での平和学習の様子です。
今日の給食(11/25)
【今日のメニュー】
〇麦ご飯、牛乳
〇おでん煮
〇ごま味噌酢和え
給食にも冬のメニューが入ってきました。
【体も心も温かくなりますよねぇ!おいしくいただきました。】
旅する美術教室(小6、中3)
11月22日(火)、「旅する美術教室」の様子です。
県立美術館の方に来ていただき、小学6年生、中学3年生を対象にした楽しい教室を開いていただきました。
テーマは「日光写真で自画像を作ろう。~目指せピカソ~」です。さぁ、どんな創造性あふれる作品が完成したのかご覧ください。

【アートペーパーの上に、身近な小物を使って自画像を形作ります。】
【窓際に持って行き、光を当てます。すると、なんということでしょう!】
【あ~ら不思議・・・】
【顔が浮かび上がってきました。作者そっくりですね?】
【そのまま紙にはさんでラミネートすると、もう消えません!】
【大喜びの生徒達・・・】
【豪華な額に入れたら完成です!】
それでは、ピカソに負けない芸術作品の数々をご覧ください。
美術(図工)には、様々な表現方法があることを学び、創造力をはたらかせて創作することの楽しさ、喜びを実感することができた子ども達です。
県立美術館からはるばる来校していただき、素敵な教室を開いていただき、誠にありがとうございました。
修学旅行特集⑧(2日目スタート!)
ホテルでは・・・
【ルームメートとくつろぎ・・・。】
【1日目のまとめをしっかり書き・・・】
【↑よっぽど楽しいことがあったんだね!】
【ぐっすりと眠り、疲れを癒やした子ども達・・】
・・・時は流れ。
【朝食の様子。メニューは・・・】
【豪華な和食ですね!】
【腹が減っては旅ができぬ!朝からみんな食欲旺盛です!】
【寝ぼけまなこの子どももいますが・・】
【みんな元気に2日目スタートしています。(退所式の様子)】
今日は、平川動物園、知覧特攻平和会館が主な見学地です。
2日目も生き生きと学習を続ける6年生の様子をお届けしていきます。どうぞお楽しみに!
~つづく~
修学旅行特集⑦(豪華ディナー編)
今日1日、見て、聞いて、動いて、自主的にしっかりとした態度で学んだ6年生・・・。
現在、豪華ディナーに舌鼓を打っているところです。
【⬇これが今晩のスペシャルディナー】
【どれから食べていいのか迷いますね!】
【フードファイター揃いで、ご飯のジャーを空にしたそうです!】
【先生達も元気そうでなにより!】
ホテルでゆっくり休んで、1日の疲れを癒やしてくださいね!
それではみなさん、また明日、お会いしましょう!
~おやすみなさい~
修学旅行特集⑥(ホテル到着!)
維新ふるさと館で・・・、
明治維新のヒーローを学習した後・・・、
ホテルに到着しております。
【児童代表あいさつ】
この後、ホテル編をお届けします!
~つづく~
修学旅行特集⑤(自主研修編)

本日の午後の学習メニューに入っています。まずは、「自主研修」です!
「鹿児島博物館」「メルヘン館」「文学館」「黎明館」etc、自分たちが興味をもった場所を訪問しました。
【鹿児島県立博物館にて】
【西郷さんの銅像前にて】
何を学んできたのか、帰ってからの「修学旅行のまとめ」を楽しみにしています。
この後、維新ふるさと館で学習した後、ホテルです。
~つづく~
今日のランチ(修学旅行編)
お腹ペコペコの子ども達・・・
旅の楽しみ、食事編です!
【今日のランチメニュー】
【鹿児島名物「黒豚肉」のしょうが焼きですね!】
【いただきま~す!】
【う~~まっ!!】
【うまアイ~~ン!(みんないい表情です!笑)】
この後は・・・
【鹿児島の町をぶらり旅・・・。自主研修です!】
~つづく~
修学旅行特集④(いおワールド編)
【水族館到着!さぁ、どんな魚たちとの出会いが待っているのでしょうか?!(ある人物との出会いもありましたよ~)】
【いお(魚)のパラダイスや~~!】
【1番のおめあてイルカショーが始まるよ~~!】
ん???この写真に見たことのある人が映っています。わかりますか?答えは1番最後で・・・。(ヒント:子ども達が偶然再会して大喜びした人物です!)
【すごいジャンプ力に感動!】
【迫力のイルカショーに大満足!】
この後・・・
【ショッピング!(レシートをもらい、小遣い帳をつけ、お金の使い方についても学習していきます。)】
では、答え合わせ・・・。この水族館で偶然出会った人物とは・・・
【5年生の時の担任、柳田先生です!(先生も修学旅行で来ていたのだそうです。運命の再会ですね!)】
~つづく~
今日の給食&上学ニュース!(11/24)
【今日のメニュー】
〇麦ご飯、牛乳
〇鯖ごま味噌煮、きゅうりのゆかり和え
〇根菜汁
上学ニュース!
今日と明日、中学部は・・・
【定期テストです!】
【今日は、「英語」「理科」「保体」】
【これまでの努力が報われることを願っています!】
↓テスト勉強に励む生徒達・・。
修学旅行特集③(桜島編)
あっという間に・・・
【桜島到着です!(有村溶岩展望所にて・・)】
ご覧のとおり、青い空、雄大な桜島のもと・・
【元気いっぱいの子ども達です!】
現在は・・・
【フェリーの旅を満喫し・・・】
【彼が見つめる先にある・・・】
鹿児島水族館に到着しております!
【次回、鹿児島水族館「いおワールド」編、お楽しみに~!(謎の旅人より・・・)】
~つづく~
修学旅行特集②
上学修学旅行ご一行様・・・
【快適なバスの旅を続けております。】
【山之口SAにて・・・。】
【霧島連山が見えてきました!】
次回は多分、桜島の写真をお見せすることができるでしょう!お楽しみに!
~つづく~
修学旅行特集①(小6)
W杯日本の大金星!そして、本日晴天なり・・。
とっても気持ちの良い朝・・・。
小学部6年生、修学旅行へ旅立ちます。
【ちょっと寂しそうな?保護者の皆さん・・】
6:30全員集合!
【いざ!出発式です!】
【校長先生の話】
【36時間ともに過ごす、仲間との絆を深めて欲しい。】
【児童代表の言葉:大きな声で堂々と、旅への決意を語ってくれました。】
【2日間お世話になる、運転手さん、バスガイドさん、添乗員さん。よろしくお願いします。】
それでは6年生諸君・・
【よい旅を!】
【いってらっしゃ~~い!】
【いってらっしゃ~~~い!】
前回の中学部修学旅行同様、画像が届き次第、ホームページにアップしていきます。どうぞお楽しみに!
性教育セミナー(中学部)
11月21日(月)、ベネッセコーポレーション株式会社主催、中学部女子&中学部3年生男子対象の「月経をテーマとした性教育セミナー」が行われました。
【中学部女子】
【中学部3年男子】
まずは男子の様子から・・・
【生理とは?「生理期間の女性の変化」「女性の悩み」等の説明】
【生理用品について知る。】
【気付いたことについて発表する生徒達】
【実際に触ってみたり、吸水性を確認したり、処分の仕方を経験したり・・・。】
正しい知識を得ることで、たとえ自分が経験していないことでも、誰かの困りや悩みに寄り添うことができることを学びました。
一方女子は・・・
【「生理のメカニズム」「経血」「PMS」等について・・】
【生理用品の種類、最新情報等・・・】
女性の日常とは切っても切り離せない生理についての理解を深め、学校生活への不安の払拭につながる良い機会となりました。
ベネッセコーポレーションの皆様、貴重なセミナーを開催していただき、誠にありがとうございました。
今日の給食&上学ニュース!(11/22)
【今日のメニュー】
〇麦ご飯、牛乳
〇鶏の唐揚げ(キャベツレモン和え)
〇さつまいものみそ汁
〇エクレア

今日はご覧のとおりスペシャルメニュー!本校6年生のリクエスト献立です。
6年生はきっとウキウキ、ワクワク、給食の時間を待っていたことでしょう!?
実は、6年生にとって、もう一つテンションが上がる理由が・・
11/24(木)25(金)と、この1年のメインイベントと言ってもいい、「修学旅行」が待っているからです。
【修学旅行事前学習会の様子】
【すみからすみまで、旅行のしおりを確認していきます。】
間に合うか心配だった・・・
【平和を願う千羽鶴も・・・】
【ついに・・・】
【完成です!】
明日は、休日。旅行の準備を完璧にし、ゆっくり休んで体調を整えておきましょう!
土木の日体験学習②

ドキドキワクワク・・・。土木に関する様々な体験活動の様子です。
【ザザツカッ、ザザッ!ザザツカッ、ザザッ!・・・・(ター〇ネーター風に)重機試乗コーナー】
【小さな力で、大きな仕事をするマシーンに感動!】
【実際に操縦して、タイヤをつかみます!(何個つかめるかな?)】
【何に乗ってるの?少し不安そうな表情の子どもも・・・】
【「高っ!」大木のはるか上空へ!(高所作業車試乗体験)キャーキャー言いながらも喜ぶ子どもたち。ちょっとしたアトラクションでした!】
【1,2,3,・・・。歩幅を使って、距離を予想中】
【実際に測量してみると・・・。この機械、なんて楽なんだ!】
【へ~~~んしん!】
【3D体験。地図が、衛星写真のように浮かび上がってきます。】
【上空から、ドローンによる・・・】
【記念撮影!(さすがのドローンも「はい、チーズ!」とは言ってくれませんでしたが・・・)】
【最後に、植栽体験。これから大切にお世話して、卒業式を彩ります。】
もう、紹介しきれないくらい、たくさんの貴重な体験をさせていただき、大満足の子ども達です。
この土木の日体験学習のために、ご尽力くださった「高鍋土木事務所」「建設業協会青年部」「測量設計事業協同組合」「造園業協会&高鍋緑心会」の皆様、本当にありがとうございました。
土木の日体験学習①
11月18日(金)に行われた、小学部5、6年生「土木の日体験学習」の様子です。
そもそも、土木の日って何???
【十一月十八日の漢字から「土・木・の・日」
まずは、高鍋土木事務所の方から、「土木の役割」について説明していただきました。
【土木の役割は、「みんなの生活を豊かにすること」】
【土砂崩れが起こる仕組みや砂防ダムの役割について・・・】
【模型を使い、分かりやすく説明していただきました。】
その頃運動場では・・・
「造園業協会&高鍋緑心会」の方々に、庭園の剪定作業をしていただきました。おかげで・・・
【見違えるように、美しく、整った環境に生まれ変わりました。ありがとうございました。】
~土木の日特集「つづく」~
この後は、子ども達がとっても楽しみにしていた・・・
【体験活動です!お楽しみに!】
今日の給食&上学ニュース!(11/21)
【今日のメニュー】
〇セルフバーガーパン、牛乳
〇鶏の照焼パティ
〇白菜スープ

白菜といえば、鍋料理ですねぇ!みなさんは、何鍋が好きですか?
白菜は、どんな鍋料理にも名脇役(時には主役に・・)として欠かせない存在です!
今日は、白菜スープ・・・
【心も体も温まりました!】
【ハンバーガーとの相性もバッチリでした!】
上学ニュース!
11月17日(木)、本校に、と~っても・・
【かわいいお客さんが来てくれました!のぞみ保育園の年長さんです。】
勤労感謝の日が近いということで、校長先生に・・・
【「お仕事頑張ってくださ~い!」お花と小物入れのプレゼントです!】
【カメラマンにもくれるの!?ありがとう!!おしごとがんばります!(ちょっと怖がってる?
)】
【小学生のお兄ちゃん、お姉ちゃんが一生懸命勉強している様子を見学した後は・・・】
【中庭で、ちょっと大きめの遊具で遊びます!】
【来年度本校入学予定の2人!楽しみに待ってますよ~!】
(番外編)
【かつて、のぞみ保育園に通った中学部3年生。理科室の窓越しにて・・・】
【園長先生と感動の再会!】
9年ぶり?の再会に大喜びの生徒達でした!!
農業体験学習(中学部1年生)
【農業体験学習事前学習会の様子】
事前学習会で、「農業の町新富町」についてしっかりと学んだ生徒達。
11月18日(金)・・・
【いよいよ実地体験です!】
地域の農家の方々5件に協力していただきました。
子ども達がやる気満々、農家の仕事を体験している様子をダイジェストでお送りします。
〇 松浦様(酪農)
【牛舎の清掃体験】
〇 神田様(園芸)
【ズッキーニの箱作り、箱詰め作業等】
〇 大﨑様(畜産)
【餌やり、牛舎の掃除】
【羊さんとも仲良くなれましたね!】
〇 猪俣様(園芸)
【ニラ収穫後の手入れ】
〇 有田様(畜産)
【仕事の説明、牛舎の掃除等】
地域の方々のご協力のおかげで、毎年、貴重な体験学習をさせていただいております。
今年も、大変お忙しい中にもかかわらず、快く引き受けてくださり、誠にありがとうございました。
作文がラジオで放送されます(11/21)
11月21日(月)、児童の作文が、MRTラジオ「私たちの作文」で放送されます。
〇 4年生 池田真友那さん 題名「体育大会の目標」
〇 時間 16:50から
おめでとうございます!
新聞掲載のお知らせ(11/19)
11月19日(土)付、宮日こども新聞「学園歌壇」コーナーに、4年生、家光 楓花さんの作品が掲載されました。
おめでとうございます!
【掲載作品】
朝の声コケコッコーで目を覚ます すずしい風と緑の夏色
社会科見学②(4年生)
おいしいお弁当を食べ、おもいっきり遊んだ後は・・・
【県庁見学です!】
【いざ、テレビで見たあこがれの場所へ・・・】
【県庁や県議会の役割について学ぶ子ども達】
【緊張気味?ゴージャスなレッドカーペットの上で正座!】
【え~~。そんなところに座ったら怒られるよ!?】
*安心してください。子ども達の学習のために体験させていただきました。ありがとうございました。
【あ~、○○君、ご静粛に!】
【議長!!僕は、昼休みの遊びはドッジボールがいいと思います!(なんちゃって・・)】
【「百聞は一見に如かず」これで、社会科の学習もバッチリですね!】
~社会科見学(4年生)「おしまい」~
社会科見学①(4年生)
中学部修学旅行の期間、他の学年でも貴重な体験学習が行われています。
まずは、11月17日に行われた4年生社会科見学からです。
【最初の見学地は、宮崎科学技術館です!科学の不思議さ、面白さを存分に味わいました。】
【てこの原理ですね!(アルキメデス曰く「我に支点を与えよ。されば地球も動かさん!」)】
【お~~~!かっこいいねぇ!でも、君はいったい何を見つめているのかな??(ちょっと怖いぞ・・)】
【お昼寝の時間?いやいやプラネタリウムの時間ですね!しっかり、お星様のお勉強をしましたとさ・・
】
科学技術館でたっぷり頭と体をはたらかせた4年生・・・
【宮崎市中央公園に移動してお弁当の時間です。】
【中には、全部自分で作った子もいたそうですよ!4年生ってすごいんですね!】
~つづく~
修学旅行特集⑮(最終回)
予定通り18:30・・・

【おかえりなさ~い!】
【おかえりなさ~~~~~い!(職員一同より)】
全員元気に、全てのミッション終了です!
この旅行のスローガン
「Do our best!考え学び お互いenjoy 助け合い!」
このスローガンのとおり、よく学び、笑い合い、クラスの絆を深めることができた3日間となりました。この経験をこれからの学校生活にも、きっと活かしていってくれることでしょう。期待しています。
引率された先生方、本当にお疲れ様でした。また、添乗員さん、バスガイドさん、運転手さん、ありがとうございました。
~中2修学旅行特集「完」~
修学旅行特集⑭(グリーンランド編②)
グリーンランド続きです!
【お~~~!地に足が着かない・・。怖そう~!】
【みんなおそろいで買ったサングラス装着!】
【こっちもおそろ!】
【水の上を颯爽と走っているけど・・・】
【安全運転でね!運転手はドキドキ・・・?】
【濡れなかった???】
【「もう!びしょびしょですよ~!」(やっぱり・・・。)】
【た~くさん乗り物に乗って、た~くさんお買い物して・・・】
【大満足ですね!】
全ての行程を終えた上学修学旅行ご一行様、帰路についています。
帰校時刻は予定通り、18:30です。
【もうすぐ帰りま~~す!】
【お土産待っててね!(その笑顔が最高のお土産ですよ!
)】
~次回最終回~
修学旅行特集⑬(グリーンランド編)
1番最後の見学地。そして、最も子ども達が楽しみにしていた場所・・
【グリーンランド到着!】
【さぁ、遊ぶぞ~~!それにしてもいい天気ですねぇ
】
【今から、絶叫マシン???】
~つづく~
今日の給食(11/18)
【今日のメニュー】
〇麦ご飯、牛乳
〇鶏肉とカシューナッツの炒め物
〇きのこ汁
修学旅行特集⑫「学問の神様編」
上学修学旅行ご一行様、最初の見学地「太宰府天満宮」参拝を終わり、現在三井グリーンランドへ向かっているところです。
【学業成就!!】
【おみくじを引き、真剣な表情で眺める生徒2名・・。結果は?】
【一目瞭然!】
【願い事が叶いますように・・・】
~次回「グリーンランド」編~
11月④12月①
今年も最後の1か月…1年が経つのは早いですね。11月の終わりから、身体を温めるメニューが多くなってきました。おでんにポタージュ、豚キムチ丼です!チリコンカンも給食によく出るメニューの一つですね。メキシコ風のアメリカ料理です。チリコンカンはスペイン語で「チリコンカルネ」と呼ばれ、「チリ」は「唐辛子」、「コン」は「と」、「カルネ」は「牛肉」という意味があります。名前の通り牛ひき肉をチリで煮込んだ料理で、そこに定番食材の豆やトマトを入れ、栄養バランスの良いメニューとなっています。(給食には、唐辛子は入っていません。)献立表を見るとき、メニュー欄だけでなく、使われている食材や調味料の欄もぜひ見てほしいと思います(*^_^*)
11月①ヴィアマテラスの選手と(*^^*)
11月5日(水)は、ヴィアマテラス宮崎の選手が9名来校し、子どもたちと一緒に給食を食べました。この日のメニューは「米粉パン、牛乳、秋のかおりシチュー、花野菜サラダ」でした。シチューの中には、秋を代表するさつまいもやしめじがたっぷり入っていました。選手や学級の仲間と食べる給食はとてもおいしかったですね!一人で食事をするより、食事をする相手がいる方がより幸せを感じるそうです(*^▽^*)給食の後は、選手と一緒に運動場でサッカーをしたりおにごっこをしたり、みんなで楽しい時間を過ごすことができました!
9月③④⑤
9月後半の給食です。みんなが大好きなポークカレーにバーガーパン、豚キムチ丼!イタリアンスープの中には、ラビオリが入っていました。(ラビオリとは、パスタ生地の中にひき肉や野菜、チーズなどを挟んだものです。)そして、9月最後の日には「うなぎのかば焼き」が出ました(*^^*)今年も中村養鰻場さんからの提供により、おいしいうなぎを食べることができました。ありがとうございました。栄養価の高いうなぎは、体育大会の練習をがんばっている子どもたちにぴったりの食材です。今日から10月…体育大会までのこり2週間です!(^^)!早寝早起き・朝ご飯はもちろんのこと、バランスのよい食事を心がけて、万全の体調で臨みましょう!
7月③★夏休みがはじまるよ!★
7月最後の週は、チャンポンにホットドックパン!シメは、夏野菜カレー(^_^)なすやピーマンがたくさん入っていました。おいしい給食を毎日ありがとうございました。みんなもりもり給食を食べているかなと教室をのぞいてみると、上新田から転校する子と別れを惜しんで、みんなで給食を食べている姿が見られました。さびしいですね…でもきっと新しい学校でもがんばってくれることでしょう。上新田っ子、みんなで応援していますよ!(8月の給食へとつづく~)
7月①②~給食試食会~
夏休みまで、のこり1週間…子どもたちは、厳暑の中よくがんばっています。7月に入って、季節にちなんだ花野菜サラダや七夕ゼリーが出ました。涼を感じるメニューでしたね。7月10日(木)は、給食試食会が行われ、保護者の皆様に学校給食の献立や味、栄養を知っていただく機会となりました。今年も新田学園の栄養教諭・渡部先生を講師としてお招きし、給食の栄養バランス等についてお話していただきました。保護者の皆様は「毎日、給食食べたいね。」「おいし~い!」と笑顔いっぱいでした(*^_^*)今週は、子どもたちが大好きなホットドック、そして夏野菜カレーで1学期をしめくくります。登校するのもあと4日!元気に過ごしましょう~
〒889-1406
宮崎県児湯郡新富町大字新田17053番地8
電話番号(小)0983-35-1016
(中)0983-35-1017
FAX (小)0983-35-1305
(中)0983-35-1286
E-mail 4520ja@miyazaki-c.ed.jp
本Webページの著作権は、「学びの丘 上新田学園」が有します。無断で、文章・画像などの複製・転載を禁じます。
【校訓】

| 日 | 月 | 火 | 水 | 木 | 金 | 土 |
29 | 30 | 31 | 1 | 2 | 3 | 4 |
5 | 6 | 7 | 8 | 9 | 10 | 11 |
12 | 13 | 14 | 15 | 16 | 17 | 18 |
19 | 20 | 21 | 22 | 23 | 24 | 25 |
26 | 27 | 28 | 29 | 30 | 1 | 2 |